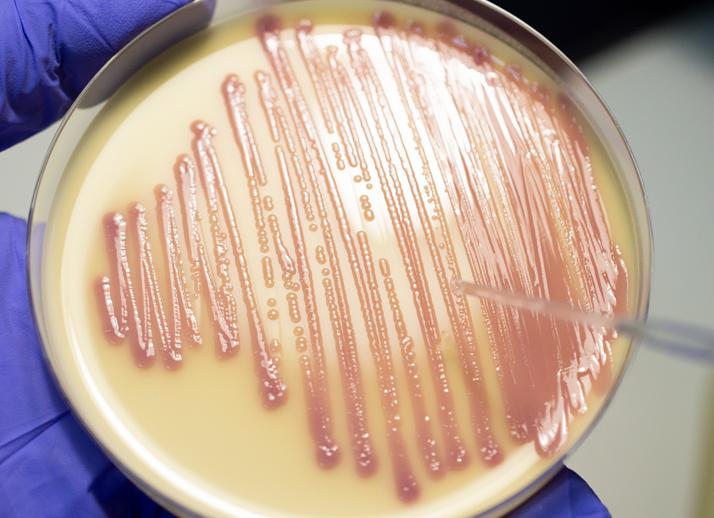
Микрофлора обильная палочковая что это Микрофлора обильная палочковая что это

Флора палочковая обильная что это значит Не только популярные анализы крови и...
Лактоморфотипы в скудном количестве что это значит Лактоморфотипы в большом количестве —...
Микрофлора кожи Микрофлора кожи – полезные микроорганизмы, наши постоянные «сожители» прекрасно приспособлены...
Микроэлементы в организме человека и продуктах питания. Таблица самых важных микроэлементов и...
Гипохромия микроцитоз причины Связанные с: уменьшением поступления железа с пищей (вегетарианство или...
Понятие микроцитоза, и как он отображается в общем анализе крови больного? Прохождение...
Микроцитоз в общем анализе крови Для диагностики многих заболеваний используются анализы крови....
Микроцитоз и гипохромия характерны для — Все про гипертонию Многие годы безуспешно...
Микроцитоз: что это, причины возникновения микроцитарных состояний, последствия Содержание: Важным и надежным...
Микроцитоз что это такое Связанные с: уменьшением поступления железа с пищей (вегетарианство...